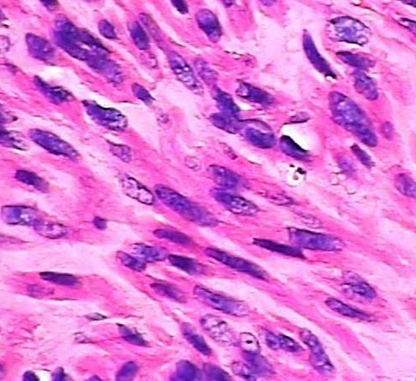
产品封面图

万千商家帮你免费找货
0 人在求购买到急需产品
- 详细信息
- 文献和实验
- 技术资料
- 服务名称:
病理学技术服务
- 提供商:
伊莱博生物科技(上海)有限公司
项目介绍:
Transwell小室的底层为聚碳酸酯膜,实验时将其置于细胞培养板中,小室内称为上室,培养板内称下室。将细胞接种在上室,由于聚碳酸酯膜具有通透性,使下层培养液中的成分可以影响到上室内的细胞,从而可以研究下层培养液中的成分对细胞生长、运动的影响。应用不同孔径的和经过不同处理的聚碳酸酯膜即可以对细胞共培养、细胞趋化、细胞迁移、细胞侵袭等多种性状进行研究。
实验流程:
细胞培养→接种细胞→细胞染色→细胞计数→观察拍照
结果提供:
实验结果图、数据和实验报告
科研实验服务:
1.基因组学:基因芯片、SNP检测、DNA甲基化检测、生物信息学分析
2.转录组学:microRNA芯片、LncRNA芯片、表达谱芯片、RNA-seq
3.蛋白质组学:2D-DIGE、SILAC、iTRAQ、TMT、Label-free、MRM
4.基因检测:DNA/RNA提取、RT-PCR、Real-timePCR
5.蛋白质检测:Western blot、Co-ip EMSA、CHIP、免疫荧光、ELISA
6.病理检测:HE染色、特殊染色、组织切片、免疫组化、流式细胞分选
7.代谢组学:GC-MS、LC-MS、NMR
8.细胞及动物模型:原代细胞、细胞模型、动物模型构建
风险提示:丁香通仅作为第三方平台,为商家信息发布提供平台空间。用户咨询产品时请注意保护个人信息及财产安全,合理判断,谨慎选购商品,商家和用户对交易行为负责。对于医疗器械类产品,请先查证核实企业经营资质和医疗器械产品注册证情况。
文献和实验),也可认为是一种有通透性的支架( permeable supports )。更准确地说, Transwell 应该是一种实验技术,这项技术的主要材料是 Transwell 小室( Transwell chamber , Transwell insert ),其外形为一个可放置在孔板里的小杯子,不同厂家对 Transwell 会有不同的命名,而不同型号也可有不同形状,不同大小,根据实验需要,可有不同选择。但无论是何种外形,其关键部分都是一致的,那就是杯子底层的一张有通透性的膜 ,而杯子其余部分
(Membrane filters),也可认为是一种有通透性的支架(permeable supports)。更准确地说,Transwell应该是一种实验技术,这项技术的主要材料是Transwell小室(Transwell chamber,Transwell insert),其外形为一个可放置在孔板里的小杯子,不同厂家对Transwell会有不同的命名,而不同型号也可有不同形状,不同大小,根据实验需要,可有不同选择。阅读全文 Transwell 实验用品 我的课题涉及Transwell侵袭实验
做肿瘤研究的人,很少有不知道 transwell 实验的,它是用来研究肿瘤细胞的迁移侵袭转移情况的一种简便快捷的实验方法,还可以构建两种细胞的共培养体系以及趋化性试验。今天咱们就来讲讲怎么做肿瘤细胞的侵袭转移实验。Transwell 侵袭实验,其实原理简单地说就是用一层膜将高营养的培养液和低营养的培养液隔开,细胞放在低营养的培养液里,为了找吃的,细胞会往高营养的培养液里面跑,但是有膜挡着,所以要穿过膜才行。我们在膜上涂上一层基质胶,模仿细胞外基质,于是细胞就要分泌金属蛋白酶将基质消化
技术资料暂无技术资料 索取技术资料